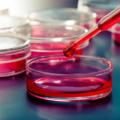

Argomenti trattati
Se il bambino non cresce è possibile che sia a causa della celiachia. Ma come si può averne la certezza e iniziare subito il giusto trattamento? Ora la diagnosi è possibile con un semplice test del sangue. Come spiega Maurizio Muscaritoli, presidente della Società italiana di nutrizione clinica (Sinu ), “nei bambini è possibile fare diagnosi di celiachia con un semplice esame del sangue che rilevi la presenza degli anticorpi specifici (TTG o EMA) in misura di dieci volte superiore ai livelli normali”.
Un test non invasivo
Si tratta, dunque, di un test semplice da eseguire e non invasivo “che rende la diagnosi più facile e meno traumatica rispetto alla precedente pratica della biopsia intestinale che individua se i villi intestinali sono atrofici e infiammati, tuttora ancora necessaria nella popolazione adulta”, precisa l’esperto.
Dieta gluten free
Il trattamento della celiachia si basa su un regime dietetico che escluda in maniera assoluta il glutine, e quindi tutti i prodotti che lo contengono: grano, ma anche segale, orzo, farro e kamut, mentre sono permessi riso e mais e i prodotti certificati per assenza di glutine.
Scomparsa dei sintomi
L’efficacia della dieta si verifica sia con la scomparsa dei sintomi sia con la diminuzione degli anticorpi, ma è da tener presente che i valori si normalizzano solo dopo 12 mesi dall’eliminazione del glutine. Anche il recupero di chili, se il bambino non cresce, è significativo rispetto all’efficacia della dieta.
Lo sapevi che?
Non solo arresto della crescita: la celiachia si manifesta sempre più in maniera camaleontica con sintomi atipici come l’anemia e la perdita di massa ossea, spie di un malassorbimento di nutrienti, mentre in altri casi i sintomi sono dermatiti e alopecia (perdita di capelli).